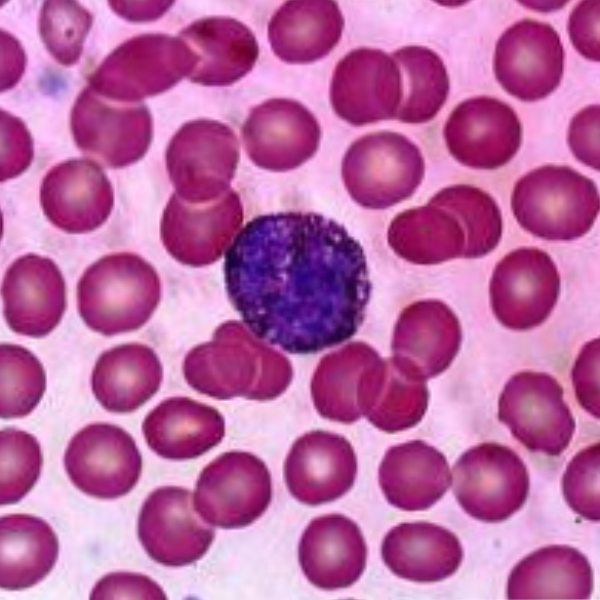
خرید لام میکروسکوپی سلول های خونی (آموزشی)

لام میکروسکوپی سلول های خونی (آموزشی)
Microscopic slide of blood cells (educational)
لام میکروسکوپی سلول های خونی (آموزشی)
Microscopic slide of blood cells (educational)
محصولات مشابه
توضیحات محصول
فروش لام سلول های خونی (آموزشی)
شرکت اینترنتی تمادکالا از فروشگاههای اینترنتی ارائه کننده انواع وسایل آزمایشگاهی است. لام میکروسکوپی آموزشی سلولهای خونی از انواع وسایل آزمایشگاهی است که توسط تماکالا به مشتریان ارائه میشود. لام آزمایشگاهی، یک قطعهی شیشهای نازک است که نمونهها برای مطالعه و بررسی در زیر میکروسکوپ روی آن قرار میگیرند. از این قطعه شیشهای بهعنوان پایه و محل قرارگیری نمونه استفاده میشود. این محصول به صورت استریل و غیر استریل میتواند تولید شود. لام آزمایشگاهی شیشهای از جنس شیشه قلیایی آهکی یا شیشه بروسیلیکات است و جنس پلاستیکی آن از پلی استایرن ساخته میشود. معمولا با ابعاد 1 × 25 × 75 میلیمتر تولید میشود. این ابعاد با توجه به کاربرد میتواند متفاوت باشد. گاهی از لامل با قرار گرفتن روی سطح لام، برای مشاهده نمونه ها استفاده میشود. گاهی گوشه های این محصول جهت آسیب نزدن به دست هنگام کار، گرد تولید میشود.
به منظور سهولت کار، لام های آموزشی لامهای آماده شده و دارای نمونه هستند که جهت آموزش در مدارس و مراکز آموزشی تولید شده اند. این لام ها قابل استفاده در آزمایشگاه مراکز آموزشی هستند. یکی از انواع این لامها، لام میکروسکوپی سلول های خونی است که انواع لامهای هماتولوژی یا خون شناسی میباشد.
ویژگی لام سلول های خونی (آموزشی)
- دارای سطح صاف و صیقلی و از جنس شیشه بوروسیلیکات
- سهولت جابهجایی نمونه زیر میکروسکوپ
- امکان نامگذاری و برچسبگذاری نمونهها
کاربرد سلول های خونی (آموزشی)
- قابل استفاده برای آزمایشگاههای زیست شناسی و بایو
- برای جابهجایی نمونهها
- نگهداری نمونههای آزمایشگاهی و نمونههای کشت بافت جهت بررسی در زیر میکروسکوپ
- برای بررسی بافت و ساختار سلول های خونی زیر میکروسکوپ
نکات مربوط به لام
- لام میکروسکوپ مرغوب باید سطح صاف و شفاف و بدون خش داشته باشد.
- باید سطح آن کاملا تمیز باشد و هیچ آلودگی و غباری روی آن نباشد.
- لام آزمایشگاهی باید استحکام مناسبی داشته باشد.
- برای سهولت کار با لام، لبههای آن صیقل داده شده باشد.
- برای پاک کردن لام ها از الکل استفاده نکنید و با یک دستمال نرم و تمیز و خشک به آهستگی روی لام را تمیز کنید.
- بهترین نحوه نگهداری لام در جعبه لام و بصورت عمودی است.
- لامهای میکروسکوپی را در جای خشک و خنک و دور از تابش نور آفتاب نگهداری کنید.
- از نگهداری جعبه های حاوی لام در مجاورت مواد شیمیایی به دلیل خاصیت خورندگی خودداری کنید.
- در صورت نیاز به استفاده از روغن ایمرسیون فقط یک قطره روغن و فقط روی لامل به آرامی بچکانید و پس از اتمام کار حتما روغن را با دستمال پاک کنید.
خرید لام سلول های خونی
لام میکروسکوپی سلول های خونی (آموزشی) را تمادکالا با کیفیت و قیمت مناسب به خریداران ارائه میکند. شما میتوانید این محصول را از همین صفحه به صورت آنلاین سفارش دهید.
اطلاعات تکمیلی
اطلاعات تکمیلی |
|---|








